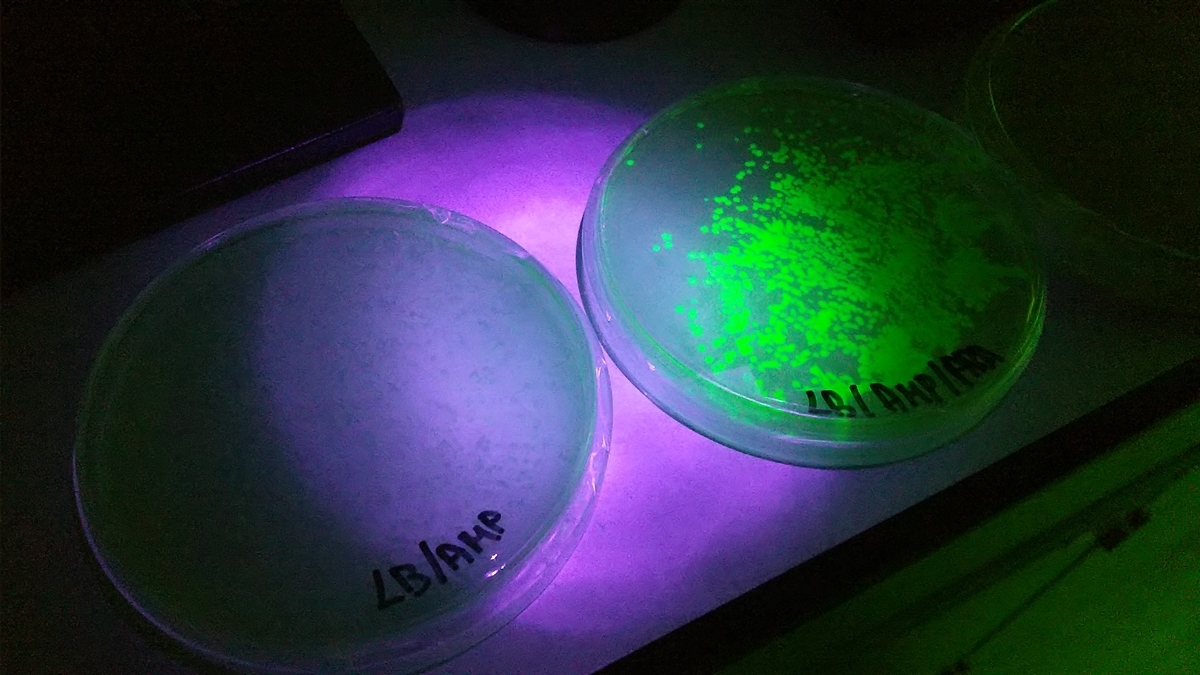

School-based Biotechnology Curriculum: Empowering Students for the Future
Our school embraces the power of STEM education to prepare students for a rapidly changing world. With this in mind, we offer a comprehensive biotechnology curriculum for junior students, where they explore the intersection of biology, chemistry, and engineering.Inquiry-based learning is a cornerstone of our curriculum, allowing students to conduct advanced experiments involving animal cell culture and plant tissue culture. Engaging in hands-on experiments, data analysis, and informed decision-making, they develop crucial critical thinking and problem-solving skills.
To facilitate their learning, our school boasts state-of-the-art facilities and advanced equipment, including real-time PCR, DNA fingerprinting, and incubators for culturing animal cells, plant cells, and bacteria. This enables students to gain practical experience with cutting-edge biotechnology techniques, fostering technical expertise, creativity, and innovation.
By introducing biotechnology into our junior curriculum, we equip students with a solid foundation in scientific principles, critical thinking skills, and an understanding of real-world applications and ethical considerations. This holistic STEM education empowers our students to thrive in a world where biotechnology continues to shape our future